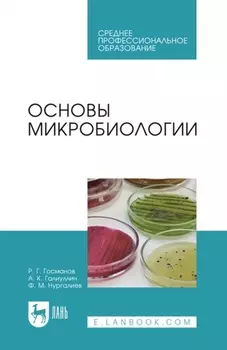
Основы микробиологии. Учебник для СПО

-
 None69 ₽
None69 ₽Целиком | В основу книги легла биография Алексея Евгеньевича Зимбицкого, рассказывающего о своем жизненном становлении, начиная с юных лет в коломенском микрорайоне Колычево и заканчивая успешной упра...
-
 None8204 ₽
None8204 ₽Animal Welfare | There has been a recent explosion of active concern in matters of animal welfare. The science behind animal welfare has progressed significantly, new codes of practice and legislation...
-
 None1000 ₽
None1000 ₽Изучение исходного материала для гетерозисной селекции зернового сорго. (Аспирантура, Магистратура). Монография. | В работе на основании 5-летних исследований в Нижневолжском регионе впервые изучены и...
-
 None9173 ₽
None9173 ₽Manual of Equine Lameness | PDF. Категория: знания и навыки/учебная и научная литература/сельское и лесное хозяйство/ветеринария
-
 None1398 ₽
None1398 ₽Экономика сельского хозяйства. Учебник для вузов | В учебнике отражены закономерности и тенденции развития агропромышленного комплекса, его состав и структура, развитие рыночных отношений в отраслях с...
-
 None400 ₽
None400 ₽Селекция и новые сорта яблони | В книге приводятся данные о производстве яблок и совершенствовании сортимента в странах мира. Представлены результаты изучения особенностей онтогенеза яблони в связи с ...
-
 None790 ₽
None790 ₽Технологический проект скотоводства и овцеводства с кормопроизводством в условиях малых форм хозяйствования. (Бакалавриат, Магистратура). Монография. | Технологический проект разработан в ФГБОУ ДПО РА...
-
 None7538 ₽
None7538 ₽Herbicides and Plant Physiology | HERBICIDES AND PLANT PHYSIOLOGY Discover the latest developments in herbicide and weed biology In the newly revised Third Edition of Herbicides and Plant Physiology, ...
-
![Основы анатомии и физиологии собак. Учебное пособие для СПО]() None429 ₽
None429 ₽Основы анатомии и физиологии собак. Учебное пособие для СПО | PDF. Категория: знания и навыки/учебная и научная литература/сельское и лесное хозяйство/ветеринария
-
![Экономика адаптивных систем хозяйствования в АПК Беларуси. Теория, методология, практика]() None440 ₽
None440 ₽Экономика адаптивных систем хозяйствования в АПК Беларуси. Теория, методология, практика | В монографии изложены сущностные особенности, экономическая, экологическая и социальная роль адаптивных систе...
-
![Feline Dentistry]() None19657 ₽
None19657 ₽Feline Dentistry | The most up-to-date version of the leading resource on veterinary dentistry in cats The Second Edition of Feline Dentistry delivers a comprehensive exploration of the specific consi...
-
![Казахстан – настоящее и будущее]() None199 ₽
None199 ₽Казахстан – настоящее и будущее | Книга представляет собой сценарий 10-серийного документального фильма о Казахстане, его культуре, его людях, богатстве его недр, его современных инновациях. Здесь и н...
-
![The Feline Patient]() None16892 ₽
None16892 ₽The Feline Patient | The classic quick reference to feline medicine with essential information on diseases, behavior, clinical procedures, and more Comprehensive yet accessible, this fully updated new...
-
![Перспективы развития отрасли свиноводства. (Аспирантура, Бакалавриат, Магистратура). Монография.]() None1000 ₽
None1000 ₽Перспективы развития отрасли свиноводства. (Аспирантура, Бакалавриат, Магистратура). Монография. | Свиноводство является наиболее скороспелой, наукоёмкой и высо-котехнологичной отраслью. В работе раск...
-
![Хлеб, вино и жулики]() None149 ₽
None149 ₽Хлеб, вино и жулики | Реальная история из нашей жизни, начала девяностых годов прошлого века, когда в искусственно разорванной стране, умышленно разваливалось отечественное сельское хозяйство и перера...
-
![Пчеловодство: Мудрость Веков и Советы Мастеров]() None199 ₽
None199 ₽Пчеловодство: Мудрость Веков и Советы Мастеров | Книга для всех, кто хочет превратить пасеку в источник меда и гармонии. Для кого: Новички: Пошаговые инструкции от установки улья до зимовки. Опытные: ...
-
![Backyard Poultry Medicine and Surgery]() None9957 ₽
None9957 ₽Backyard Poultry Medicine and Surgery | Backyard Poultry Medicine and Surgery is a practical resource offering guidance on developing diagnostic and treatment plans for individual companion poultry or...
-
![Технология ремонта машин]() None739 ₽
None739 ₽Технология ремонта машин | В учебном пособии рассмотрены технологические процессы ремонта машин, содержатся элементы проектирования технологических процессов восстановления деталей и сборочных единиц,...
-
![Хранение, транспортировка, предпродажная подготовка и реализация продукции растениеводства. Учебник для СПО]() None891 ₽
None891 ₽Хранение, транспортировка, предпродажная подготовка и реализация продукции растениеводства. Учебник для СПО | PDF. Категория: знания и навыки/учебная и научная литература/сельское и лесное хозяйство/р...
-
![Инженерная экология]() None238 ₽
None238 ₽Инженерная экология | Рассмотрены вопросы состояния атмосферы, гидросферы и литосферы, влияния на них промышленного производства, сельского хозяйства, транспорта, изложены основные методы очистки выбр...
-
![Soil Health Analysis, Set]() None11974 ₽
None11974 ₽Soil Health Analysis, Set | PDF. Категория: знания и навыки/учебная и научная литература/сельское и лесное хозяйство/растениеводство
-
![Основы микробиологии. Учебник для СПО]() None644 ₽
None644 ₽Основы микробиологии. Учебник для СПО | PDF. Категория: знания и навыки/учебная и научная литература/сельское и лесное хозяйство/ветеринария
-
![Profitable Organic Farming]() None12737 ₽
None12737 ₽Profitable Organic Farming | The demand for food produced from sustainable and organic farm enterprises continues to grow worldwide, with demand exceeding supply for many items. This second edition of...
-
![Топ-50 бизнесов в сфере сельского хозяйства]() None196 ₽
None196 ₽Топ-50 бизнесов в сфере сельского хозяйства | В книге ты найдешь самые перспективные идеи для старта или расширения своего агробизнеса. Мы рассмотрим разнообразные направления: от органического землед...
-
![Новые технологии и методы оздоровительного действия против вредных объектов. (Аспирантура, Бакалавриат, Магистратура). Монография.]() None1000 ₽
None1000 ₽Новые технологии и методы оздоровительного действия против вредных объектов. (Аспирантура, Бакалавриат, Магистратура). Монография. | Монография посвящена применению новых технологий и методов оздорови...
-
![Грецкий орех. В чем его целительная сила?]() None0 ₽
None0 ₽Грецкий орех. В чем его целительная сила? | «Какое существо на Земле обладает самым большим мозгом по отношению к весу тела? Какое существо в процессе эволюции построило самую крепкую семью, не убивае...
-
![Seizures in Dogs and Cats]() None6967 ₽
None6967 ₽Seizures in Dogs and Cats | Seizures in Dogs and Cats offers a practical, complete resource for the veterinary management of seizures in dog and cat patients. The book is carefully designed for ease o...
-
![Пищевая безопасность водных биологических ресурсов и продуктов их переработки]() None2048 ₽
None2048 ₽Пищевая безопасность водных биологических ресурсов и продуктов их переработки | В учебном пособии описаны пути загрязнения сырья и продуктов переработки ВБР различными ксенобиотиками – токсичными мета...
-
![Мелиоративное земледелие. Учебное пособие для вузов]() None1021 ₽
None1021 ₽Мелиоративное земледелие. Учебное пособие для вузов | В учебном пособии излагаются основы мелиоративного земледелия с элементами оросительной, осушительной мелиорации, с расчетами применения минеральн...
-
![Гуси и утки. Содержание, разведение и уход]() None149 ₽
None149 ₽Гуси и утки. Содержание, разведение и уход | Разведение гусей и уток для получения мяса, яиц. пера и пуха – прибыльное дело. В книге содержится информация о наиболее ценных породах, о том. как содержа...
-
![Клиническое исследование животных. Учебное пособие для СПО]() None761 ₽
None761 ₽Клиническое исследование животных. Учебное пособие для СПО | PDF. Категория: знания и навыки/учебная и научная литература/сельское и лесное хозяйство/ветеринария
-
![Скрещивание в свиноводстве. (Аспирантура, Магистратура). Монография.]() None1000 ₽
None1000 ₽Скрещивание в свиноводстве. (Аспирантура, Магистратура). Монография. | В монографии представлены результаты длительных научных исследований авторов по использованию в селекционных целях скрещивания св...
-
![Смородина красная: биология, агротехника, сорта (методические рекомендации)]() None100 ₽
None100 ₽Смородина красная: биология, агротехника, сорта (методические рекомендации) | В брошюре приведены сведения о биологических особенностях, агротехнике смородины красной, основных болезнях, вредителях и ...
-
![Practical Clinical Epidemiology for the Veterinarian]() None5992 ₽
None5992 ₽Practical Clinical Epidemiology for the Veterinarian | Practical Clinical Epidemiology for the Veterinarian provides thorough coverage of the fundamentals of epidemiological concepts, situated within ...
-
![Гречиха. Учебное пособие для вузов]() None845 ₽
None845 ₽Гречиха. Учебное пособие для вузов | В пособии описаны морфология, биология гречихи и технология ее возделывания. Разработаны новые устройства для предпосевной обработки семян, оценки их качества, вне...
-
![Технологии сельскохозяйственных механизированных работ в растениеводстве и животноводстве. (СПО). Учебник.]() None1600 ₽
None1600 ₽Технологии сельскохозяйственных механизированных работ в растениеводстве и животноводстве. (СПО). Учебник. | Рассмотрены общие принципы комплексной механизации растениеводства, животноводства и птицев...
-
![Бухгалтерский, управленческий и налоговый учет как основа интегрированного учета устойчивого развития организаций АПК. (Аспирантура, Бакалавриат, Магистратура). Монография.]() None1000 ₽
None1000 ₽Бухгалтерский, управленческий и налоговый учет как основа интегрированного учета устойчивого развития организаций АПК. (Аспирантура, Бакалавриат, Магистратура). Монография. | Интегрированный учет стан...
-
![Агропромышленный комплекс ПФО России: итоги, инвестиции и цифровизация. (Аспирантура, Магистратура). Монография.]() None1000 ₽
None1000 ₽Агропромышленный комплекс ПФО России: итоги, инвестиции и цифровизация. (Аспирантура, Магистратура). Монография. | Приволжский федеральный округ (ПФО) – один из наиболее развитых агропромышленных реги...
-
![Blackwell's Five-Minute Veterinary Consult]() None9666 ₽
None9666 ₽Blackwell's Five-Minute Veterinary Consult | Blackwell’s Five-Minute Veterinary Consult: Avian presents complete information on diseases and conditions seen in birds in a quick-reference format ideal ...
-
![Radiography of the Dog and Cat. Guide to Making and Interpreting Radiographs]() None10327 ₽
None10327 ₽Radiography of the Dog and Cat. Guide to Making and Interpreting Radiographs | Radiography of the Dog and Cat: Guide to Making and Interpreting Radiographs offers a comprehensive guide to producing hi...
-
![Equine Clinical Immunology]() None13161 ₽
None13161 ₽Equine Clinical Immunology | Equine Clinical Immunology offers comprehensive information on equine immunological disorders. • Provides a complete, equine-specific reference on clinical immunology • Fo...
-
![Журнал Computerworld Россия №10/2015]() None115 ₽
None115 ₽Журнал Computerworld Россия №10/2015 | Computerworld Россия – ведущий международный еженедельник, посвященный информационным технологиям. В журнале вы найдете обзор важнейших событий ИТ-индустрии в Ро...
-
![ОПХ]() None299 ₽
None299 ₽ОПХ | Нам, жившим в советской деревне, настало время подумать: как передать потомкам, что деревня, сельское хозяйство в советское время не были чёрными дырами, в которых царили рабский труд и неизбывн...
-
![Ультрадисперсные системы: получение, свойства, применение]() None680 ₽
None680 ₽Ультрадисперсные системы: получение, свойства, применение | В учебном пособии систематизированы существующие в настоящее время методы получения ультрадисперсных материалов. Обобщены представления по м...
-
![Повышение устойчивости сельскохозяйственного развития на основе диверсификации. (Аспирантура, Бакалавриат, Магистратура). Монография.]() None1000 ₽
None1000 ₽Повышение устойчивости сельскохозяйственного развития на основе диверсификации. (Аспирантура, Бакалавриат, Магистратура). Монография. | В монографии предложена авторская методика, предусматривающая: п...
-
![Куркума: лекарство, косметика или прекрасный цветок?]() None0 ₽
None0 ₽Куркума: лекарство, косметика или прекрасный цветок? | Куркумой ланьлинское пахнет вино – изыскан его аромат. В наполненной яшмовой чаше оно пылает янтарным огнем. Пусть гостя хозяин поит допьяна – ко...
-
![Manual of Clinical Procedures in the Horse]() None11156 ₽
None11156 ₽Manual of Clinical Procedures in the Horse | Manual of Clinical Procedures in the Horse is a detailed step-by-step guide to clinical skills in equine practice. With information on techniques ranging f...
-
![Объекты интеллектуальной собственности в АПК и их правовая защита]() None1099 ₽
None1099 ₽Объекты интеллектуальной собственности в АПК и их правовая защита | В учебном пособии изложены основы правовой защиты объектов интеллектуальной деятельности: изобретений, полезных моделей, программ дл...
-
![Пленники замкнутой бесконечности]() None33 ₽
None33 ₽Пленники замкнутой бесконечности | Действие романа происходит в изолированном мирке, ограждённом от остальной части планеты невидимым и непреодолимым барьером. Вся территория замкнутого мира – долина,...
-
![Pathogenesis of Bacterial Infections in Animals]() None14961 ₽
None14961 ₽Pathogenesis of Bacterial Infections in Animals | This much-anticipated third edition again consolidates the knowledge of more than twenty experts on pathogenesis of animal disease caused by various s...
-
![Иммуногенетические приемы в системе интегрированной защиты озимой пшеницы от комплекса фитопатогенов на черноземе выщелоченном. (Аспирантура, Бакалавриат, Магистратура). Монография.]() None1000 ₽
None1000 ₽Иммуногенетические приемы в системе интегрированной защиты озимой пшеницы от комплекса фитопатогенов на черноземе выщелоченном. (Аспирантура, Бакалавриат, Магистратура). Монография. | В книге, написан...
-
![Агрометеорология]() None722 ₽
None722 ₽Агрометеорология | Учебное пособие написано в соответствии с требованиями ФГОС ВПО по направлениям подготовки «Агрономия», «Технология производства и переработки сельскохозяйственной продукции» , «Агр...
-
![Veterinary Periodontology]() None13223 ₽
None13223 ₽Veterinary Periodontology | Veterinary Periodontology is a comprehensive yet user-friendly reference on periodontal disease in dogs and cats, encompassing etiology, pathogenesis, and clinical features...
-
![Hospice and Palliative Care for Companion Animals]() None7975 ₽
None7975 ₽Hospice and Palliative Care for Companion Animals | Hospice and Palliative Care for Companion Animals: Principles and Practice offers the first comprehensive reference to veterinary hospice and pallia...
-
![Овощеводство. Учебное пособие для СПО]() None540 ₽
None540 ₽Овощеводство. Учебное пособие для СПО | PDF. Категория: знания и навыки/учебная и научная литература/сельское и лесное хозяйство/растениеводство
-
![Equine Behaviour]() None7914 ₽
None7914 ₽Equine Behaviour | Understanding the flexibility and limits of behaviour is essential to improving both the horse's welfare and its performance. This book tackles the fundamental principles which will...
-
![Grooming Manual for the Dog and Cat]() None9459 ₽
None9459 ₽Grooming Manual for the Dog and Cat | One of the responsibilities of every dog or cat owner is that of coat care. There are many and varied coat types and there is a vast difference between the time i...
-
![Хозяева Милоты]() None349 ₽
None349 ₽Хозяева Милоты | Мы написали эту книгу вместе, чтобы показать другим, как происходит спасение животных через неофициальные сообщества. Мы любим ежей и никогда не перестанем восхищаться ими. Они прекра...
-
![Fruit and Vegetables]() None33298 ₽
None33298 ₽Fruit and Vegetables | The second edition of this very well-received book, which in its first edition was entitled Postharvest Technology of Fruits and Vegetables, has been welcomed by the community o...
-
![Семенной контроль. Учебное пособие для СПО]() None793 ₽
None793 ₽Семенной контроль. Учебное пособие для СПО | В учебном пособии представлены основные разделы семенного контроля, такие как: отбор образцов для анализа, чистота семян, всхожесть семян, жизнеспособность...
-
![Waldb?den]() None6328 ₽
None6328 ₽Waldb?den | Ein einzigartiger Bildband reich an Beispielen der ma?geblichen Bodentypen. Im Fokus: die Waldgebiete Osterreichs, Deutschlands und der Schweiz. Zu jedem Bodenprofil sind umfassende Daten ...
-
![Экономика организаций и отраслей агропромышленного комплекса. Книга 2]() None339 ₽
None339 ₽Экономика организаций и отраслей агропромышленного комплекса. Книга 2 | Во второй книге освещены современные проблемы повышения эффективности функционирования организаций и отраслей АПК, особенности и...
-
![Гибридизация в свиноводстве. (Аспирантура, Магистратура). Монография.]() None1000 ₽
None1000 ₽Гибридизация в свиноводстве. (Аспирантура, Магистратура). Монография. | В монографии представлены результаты длительных научных исследований авторов по разработке и внедрению в практику новых наиболее...
-
![Blackwell's Five-Minute Veterinary Consult Clinical Companion]() None10652 ₽
None10652 ₽Blackwell's Five-Minute Veterinary Consult Clinical Companion | Blackwell’s Five-Minute Veterinary Consult Clinical Companion: Small Animal Dentistry, Second Edition presents essential information in ...
Книги по сельскому хозяйству
В категории "книги по сельскому хозяйству" найдено товаров: 4690 | Страница 31